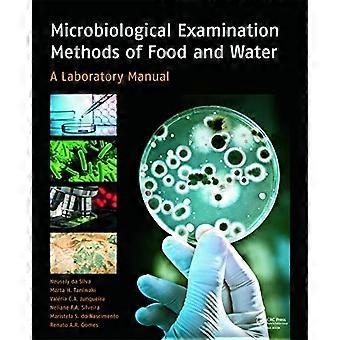

Sci-fi a fantasy
Za skvelé ceny si teraz môžete kúpiť až 64 838 výrobkov s vysokou hodnotou z kategórie sci-fi a fantasy. Nákup výrobkov sci-fi a fantasy cez Fruugo je jednoduchý, so ZĽAVOVÝMI AKCIAMI, ponukami a zníženými cenami v kategórii Hewlett Packard Enterprise, Honeywell, Dewalt a iné. Kúpte si sci-fi a fantasy online a bezpečne cez Fruugo, s možnosťou bezpečnej platby a rýchleho doručenia na Slovensko.
Filtre
2 977 - 3 008 z 3 200